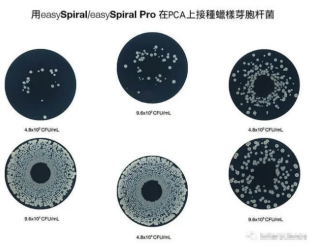
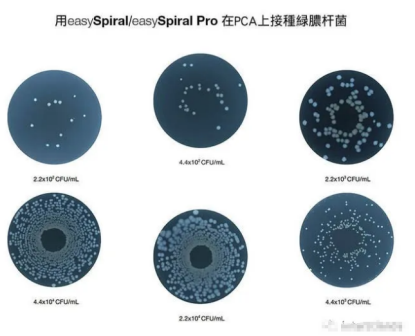

更新时间:2020-08-24
更新时间:2020-08-24 点击次数:2260
点击次数:2260
你了解螺旋方法吗?螺旋方法可以自动、标准化地接种细菌。这项技术使得我们能在一块培养皿上完成4个梯度的稀释。

样品以阿基米德螺旋的形式在培养皿表面接种(接种体积从中心到外围递减)。该体积是被校准过的,培养皿上每个点的容量都是可知的。
为什么选择螺旋方法?
使用螺旋方法能够大大提高您实验室的分析能力:无需手动连续稀释样品,即可完成一次标准化的自动接种。

l 在一个培养皿上完成100-1X107CFU/ml
l 耗材的节省可达75%
l 接种一个培养皿只需8s
如何计数?
螺旋方法使得我们能在培养皿表面接种呈对数递减的曲线。体积是被校准过的,培养皿上每个点的容量都是可知的。计数培养皿区域内的菌落数,除以该区域的接种体积,以此可计算出细菌浓度。

手工计数时,从外侧开始,至少计数20个菌落,然后在对角的1/4部分重复这一操作。

计数的小菌落数(15或20)取决于参数中定义的标准。
n : 细菌浓度,以CFU/ml为单位
N : 计数出的菌落个数
D : 样品的稀释倍数
V : 计数的区域对应的接种体积,以µL为单位(见体积对照表)

easySpiral 和easySpiral Pro
接种的培养皿实例
在PCA上接种蜡样芽胞杆菌
在PCA上接种枯草芽胞杆菌

在麦康凯培养基上接种大肠杆菌

在MRS培养基上接种干酪乳杆菌

绿脓杆菌
螺旋方法,25年的经验
1973年,FDA研究员埃德坎贝尔博士发明了螺旋方法来自动计算实验室工作中的细菌数量。此后,他和interscience的创始人François Jalenques合作开发仪器,于1992年重新校正了螺旋方法并为其申请了。
从那时起,全自动螺旋接种仪Spiral 就和XP V08-034, ISO 7218, ISO 4833-2, ISO 15189, FDA-BAM以及AOAC标准一同作为指导方法。
interscience已经推出了第三代螺旋接种仪easySpiral 和easySpiral Pro。
interscience的螺旋方法:easySpiral产品系列
Copyright © 2026 东南科仪版权所有 备案号:粤ICP备07011256号
技术支持:化工仪器网 管理登录 sitemap.xml